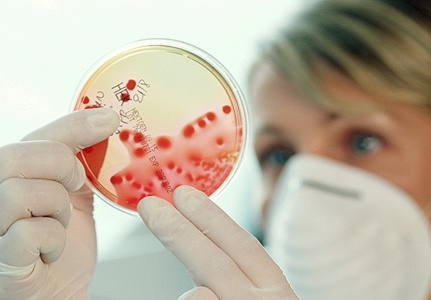

26-летний Камара недавно вернулся из расположения сборной Сьерра-Леоне, в составе которой сыграл с "Камеруном" в рамках квалификационного раунда к Кубку Африканских наций 2015 года. Руководство "Ламии" при принятии этого решения советовалось с министерством здравоохранения Греции.
Советский спорт







